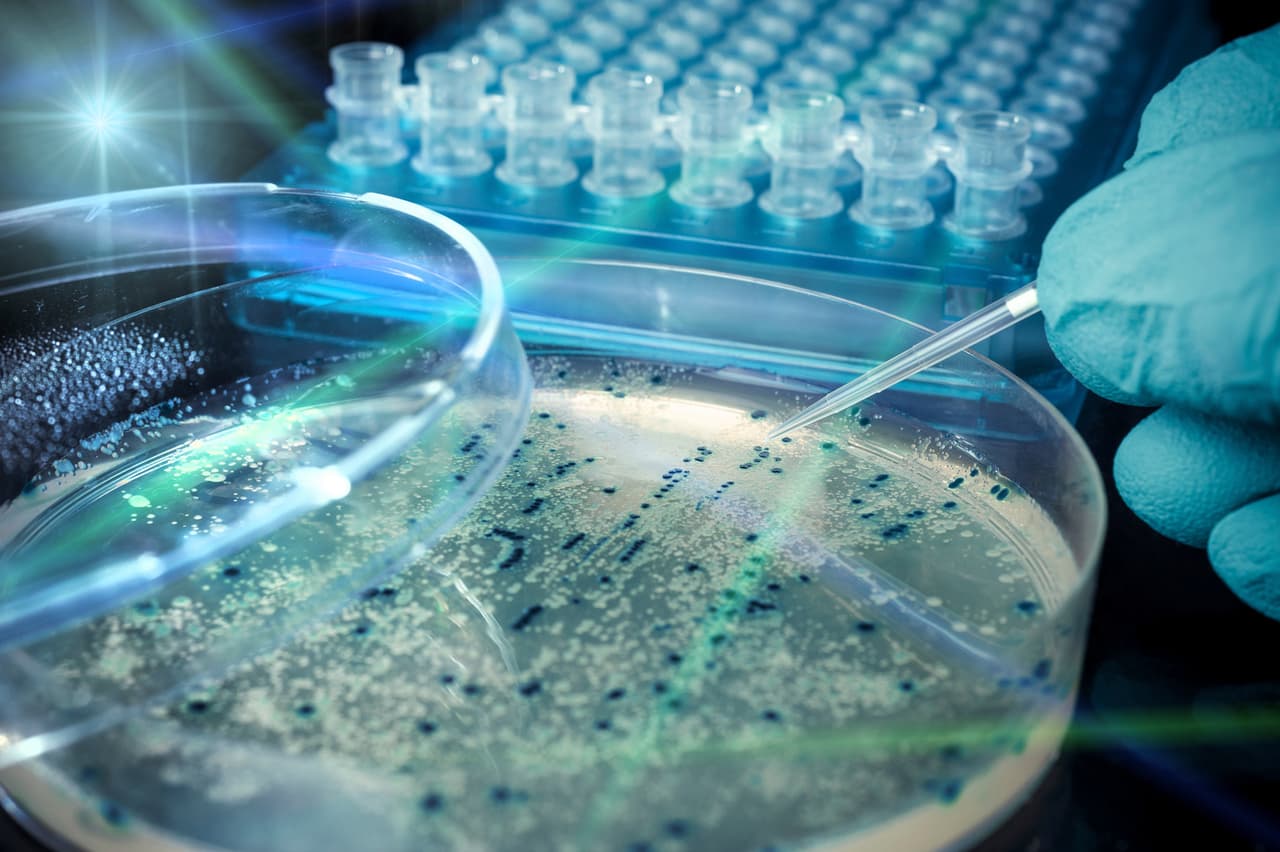
Aviso de hervir el agua queda oficialmente rescindido en la ciudad de Murphy

E. coli
E. coli: Últimas noticias, videos y fotos de E. coli
McDonald's descarta que la carne originara el mortal brote de E. coli y anuncia el regreso del "cuarto de libra"
Los Centros para el Control y la Prevención de Enfermedades (CDC) reportaron que al menos 75 personas de 13 estados enfermaron por un brote de E. coli que considera fue originado en McDonald's.
LO MÁS RECIENTE
Aumenta a 75 el número de infectados por brote de E. coli: se reportan casos en 13 estados
Los enfermos por el brote de E. coli en Estados Unidos siguen aumentando y la mayoría asegura haber comido hamburguesas de cuarto de libra de McDonald's. La Administración de Alimentos y Medicamentos (FDA) confirmó que los infectados ya suman 75 y que al menos 22 de ellos fueron hospitalizados. Dos pacientes desarrollaron una afección grave que puede causar insuficiencia renal. También puedes ver: ¿Comiste la hamburguesa Cuarto de Libra de McDonald’s recientemente? Ten cuidado si presentas estos síntomas.
Suben a 75 los casos de E. coli relacionados con las hamburguesas cuarto de libra de McDonald’s
El brote de E. coli relacionado con las hamburguesas cuarto de libra de la cadena de comida rápida McDonald’s se extiende ya por 13 estados y ha causado al menos una muerte y decenas de hospitalizaciones, según los CDC.
¿Qué hacer si sospechas haberte infectado con E. coli en McDonald's? ¿Cuáles son los síntomas de E. coli?
Lo mejor de Noticias Univision de la mañana | viernes 25 de octubre de 2024
Donald Trump y Kamala Harris continúan sus recorridos por estados clave a 11 días de las elecciones presidenciales. En otras noticias, hay expectativa por el futuro de los hermanos Menéndez tras la propuesta de un fiscal de que se les dicte una nueva sentencia. Finalmente, restaurantes de comida rápida retiran las cebollas de sus menús por brote de E. coli.

McDonald's asegura que el brote de E. coli en sus restaurantes se originó en California: ¿Por qué?
Al menos 49 personas en 10 estados han sufrido intoxicación alimentaria por E. coli tras comer en restaurantes de la cadena McDonlads, 10 de ellos terminaron hospitalizados. Ahora la empresa asegura que el brote se originó en California. Esto es lo que se sabe.
McDonald's confirma que cebollas cultivadas en California originaron el brote de E. coli en sus hamburguesas
La cadena de comida rápida McDonald's confirmó que las cebollas cultivadas por un agricultor en California son el origen del reciente brote de E. coli, que ya deja al menos un muerto y varias personas hospitalizadas. La compañía enfrenta una demanda interpuesta por un hombre de Colorado que afirma haberse enfermado tras comer una de sus hamburguesas de cuarto de libra. También puedes ver: ¿Comiste la hamburguesa Cuarto de Libra de McDonald’s recientemente? Ten cuidado si presentas estos síntomas.
Este es el posible responsable del brote de E. coli en hamburguesas de McDonalds
McDonald’s y agencias federales buscan determinar con precisión cuál fue el ingrediente contaminado con la bacteria E. coli.